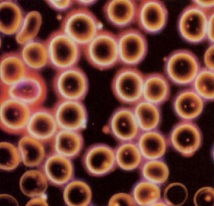

Auf dieser Seite finden Sie eine Auflistung aller ZeitenSchrift Artikel zum Stichwort Medizin.
Welche Krankheiten uns sagen: Der Körper durstet! Nicht online verfügbar Ausgabe bestellen
Die Gentechnologie soll den Welthunger besiegen und unheilbare Krankheiten heilen. So lauten die Versprechungen der Industrie. Doch wissenschaftliche Erkenntnisse zeigen: Die Genmanipulation kann uns niemals satt und gesund machen – vielmehr birgt sie riesige Gefahren.Wissenschaftliche Erkenntnisse zeigen: Die Genmanipulation kann uns niemals satt und gesund machen - vielmehr birgt sie riesige Gefahren. Weiterlesen...
Herz-Kreislauf-Erkrankungen lassen sich vermeiden! Sie sind ganz einfach die Folge eines chronischen Vitaminmangels. Dies gilt meist auch für Diabetes. Die Pharmaindustrie scheint jedoch alles zu tun, um diese revolutionäre Erkenntnis zu vertuschen. Weiterlesen...
Wie man aus Pflanzen die reinsten und höchsten Wirkkräfte gewinnt und was es mit der Transmutation unedler Metalle zu Gold auf sich hat, erfahren Sie hier von einem wahren Alchemisten. Ebenso, was die geistigen Hintergründe der alchemischen Laborarbeit sind und was die Chymische Hochzeit mit der Vereinigung von Frau und Mann gemein hat. Weiterlesen...
Ein Yorkshire-Terrier mit epileptischen Anfällen? Ein Mann mit Schleudertrauma? Eine Katze mit Angstzuständen? Eine Frau mit Depressionen? Dr. Yair Schiftan verhilft ihnen allen zu rascher Linderung ihrer Pein. Sein Rezept kennt keine Nebenwirkungen: Es heisst – Musik! Weiterlesen...
Was verursacht die geheimnisvolle Demenzkrankheit? Und wie können wir ihr vorbeugen? Alzheimer hat seine Ursache in falschen Lebens- und Ernährungsgewohnheiten. Ganzheitliche Therapien können daher nicht nur vorbeugend, sondern auch lindernd wirken. Nicht online verfügbar Ausgabe bestellen
Wird ein Mensch von Pilzen befallen, so kann daraus fast jedes Krankheitssymptom entstehen. Gerade heute sind sehr viele vollkommen unterschiedlich diagnostizierte Beschwerden letztlich nur die Folge einer Pilzinfektion. Sie kann eintreten, sobald das Säure-Basen-Gleichgewicht im Organismus nachhaltig gestört ist. Weiterlesen...
Unsere Ernährung provoziert gerne eine chronische Verstopfung des Darms. Ist der Darm chronisch verstopft, können im ganzen Körper Krankheiten und Beschwerden auftreten, denn nicht umsonst wird der Darm auch ‚Sitz des Lebens‘ genannt. Eine Kräuterkur nach Robert Gray kann den Darm reinigen. Gut zu wissen, leiden wir doch alle fast ausnahmslos an Verstopfung. Weiterlesen...
Blutmykosen nehmen in erschreckendem Ausmaß zu. Nach Enderlein sind Blutpilze jedoch nur in gewissen Entwicklungsstadien für den Menschen gefährlich. Der Schweizer Bruno Haefeli hat in jahrelangen Studien eine Möglichkeit gefunden, die Pilze im Blut zu neutralisieren. Weiterlesen...
Alle Vorgänge im Körper werden durch feinste elektromagnetische Impulse gesteuert. Deshalb bietet die 'Elektroakupunktur-Methode nach Voll' dem Arzt oder Therapeuten die Möglichkeit, direkt den Körper über den Gesundheitszustand seiner Organe zu befragen. Nicht online verfügbar Ausgabe bestellen

Unabhängiger und unerschrockener Journalismus, wie ihn die ZeitenSchrift bietet, ist wichtiger denn je. Wir können unsere Aufgabe indes nur erfüllen, wenn das Magazin von möglichst vielen Menschen gelesen wird. Mit unserem verbilligten Heftangebot soll die ZeitenSchrift weiterhin so erschwinglich wie möglich bleiben. Womit wir nämlich heute konfrontiert sind, ist die minutiöse Umsetzung eines Masterplans, der uns in die totalüberwachte und digitalisierte Welt des „Great Reset“ führen soll. Wollen Sie mithelfen, damit viele Leute unabhängig und fundiert informiert werden?
Dann können Sie von den zweiundzwanzig Ausgaben der Nummern 102-123 bis auf Weiteres drei Exemplare für den Preis von zwei bestellen, zzgl. Porto. Das gilt selbstverständlich auch für entsprechend vielfache Mengen (z.Bsp. 9 Stück bestellen und nur 6 bezahlen). Dabei können Sie frei wählen, welche und wie viele Exemplare der Ausgaben Sie zu einem "3 für 2"-Paket zusammenstellen wollen.
>> Bestellen Sie Ihre Exemplare gleich hier!
Herzlichen Dank, wenn auch Sie diese wichtigen Informationen verbreiten und zu "Verteidiger des gesunden Menschenverstands" werden.